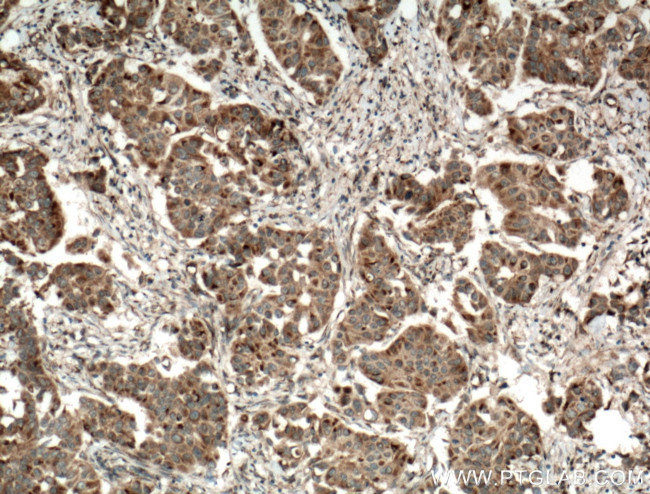
SYTL4 Antibody in Immunohistochemistry (Paraffin) (IHC (P))

Search
Proteintech
SYTL4 Polyclonal Antibody
{{$productOrderCtrl.translations['antibody.pdp.commerceCard.promotion.promotions']}}
{{$productOrderCtrl.translations['antibody.pdp.commerceCard.promotion.viewpromo']}}
{{$productOrderCtrl.translations['antibody.pdp.commerceCard.promotion.promocode']}}: {{promo.promoCode}} {{promo.promoTitle}} {{promo.promoDescription}}. {{$productOrderCtrl.translations['antibody.pdp.commerceCard.promotion.learnmore']}}
产品信息
12128-1-AP
种属反应
已发表种属
宿主/亚型
分类
类型
抗原
偶联物
形式
浓度
规格
纯化类型
保存液
内含物
保存条件
运输条件
产品详细信息
Immunogen sequence: IGSMMSIYS EAGDFGNIFV TGRIAFSLKY EQQTQSLVVH VKECHQLAYA DEAKKRSNPY VKTYLLPDKS RQGKRKTSIK RDTVNPLYDE TLRYEIPESL LAQRTLQFSV WHHGRFGRNT FLGEAEIQMD SWKLDKKLDH CLPLHGKISA ESPTGLPSHK GELVVSLKYI PASKTPVGGD RKKSKGGEGG ELQVWIKEAK NLTAAKAGGT SDSFVKGYLL PMRNKASKRK TPVMKKTLNP HYNHTFVYNG VRLEDLQHMC LELTVWDREP LASNDFLGGV RLGVGTGISN GEVVDWMDST GEEVSLWQKM RQYPGSWAEG TLQLRSSMAK QKLGL (338-671 aa encoded by BC014913)
靶标信息
This gene encodes a member of the synaptotagmin like protein family. Members of this family are characterized by an N-terminal Rab27 binding domain and C-terminal tandem C2 domains. The encoded protein binds specific small Rab GTPases and is involved in intracellular membrane trafficking. This protein binds Rab27 and may be involved in inhibiting dense core vesicle exocytosis. Alternate splicing results in multiple transcript variants that encode the same protein.
仅用于科研。不用于诊断过程。未经明确授权不得转售。
生物信息学
蛋白别名: CCB protein; Exophilin-2; Granuphilin; granuphilin b; granuphilin-a; granuphilin-b; synaptotagmin-like 4 (granuphilin-a); Synaptotagmin-like protein 4; unnamed protein product
基因别名: Gph; SLP4; SYTL4
UniProt ID: (Human) Q96C24, (Mouse) Q9R0Q1, (Rat) Q8VHQ7
Entrez Gene ID: (Human) 94121, (Mouse) 27359, (Rat) 140594